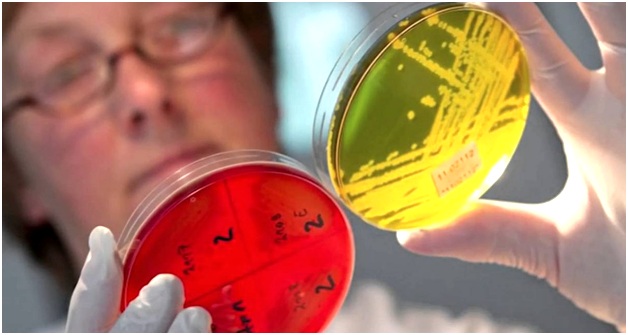
лабораторные анализы

Что такое лямблиоз? Лямблиоз – болезнь, ее возбудители простейшие одноклеточные паразиты. Они находятся в земельных почвах, одежде и вещах обихода, в воде. Они могут жить до нескольких месяцев при благоприятных условиях. Около 30% деток заражаются этими микроорганизмами. После попадания в организм деток, они мешают полноценной работе тонкого кишечника и приводят к разнообразным осложнениям.
Виды паразитов и методы заражения деток
Они могут жить в 2-х состояниях. Паразиты в подвижной вегетативной форме грушевидного вида, их длина составляет почти 0.6 мм. У них есть 8 жгутов и диск, с помощью которых они прикрепляются к стенкам тонкого кишечника.
Лямблии из вегетативной формы в цисты преобразовываются, если в толстом кишечнике нет подходящих условий. В такой ситуации у них округлая форма, в размере они примерно 1 мм, и не могут двигаться. Но подобное состояние играет огромную роль для размножения этих микроорганизмов. После опорожнения лямблии (в кале), долгое время, находясь в открытой среде, составляют риск для других, так как они могут заразиться. После проникновения в организм человека цисты остаются без оболочек и снова становятся подвижными.
Эти паразиты могут попасть к ребенку в основном тремя способами:
- Водный способ. Кроха может получить цисты лямблий, если будет пить воду из-под крана, в которой есть эти цисты. Как известно, в большинстве городов, сел вода не получает необходимое очищение, поэтому есть большая вероятность того, что малыш, попив «сырой» воды, подхватит лямблии, очень большая.
Такое может произойти и во время купания в открытых водных источниках, если зараженная вода проникнет в организм крохи. А вот купаясь в море, можно быть спокойным – в соленой воде эти паразиты не живут.
- Бытовой способ. Малыш может их подцепить, если будет пользоваться посудой, игрушками, полотенцами, которые кишат лямблиями. Особо подвержены заболеванию малыши, которые постоянно тянут в рот карандашики, ручки и в особенности ногти. Кроме этого, носителями лямблий могут быть и уличные коты, которые очень часто обитают возле детских площадок.
- Пищевой способ. Паразиты попадают в организм малыша, если он кушает немытую растительную пищу, или мясо, не подвергшееся термической обработке.
https://youtube.com/watch?v=BJNGqKCo9aw%3Frel%3D0
Врачи отмечают, что лямблиоз у детей может проявляться разнообразной симптоматикой, включая боли в животе, диарею, тошноту и потерю аппетита. Часто заболевание сопровождается аллергическими реакциями и общим ухудшением самочувствия. Важно, чтобы родители обращали внимание на эти симптомы и не откладывали визит к специалисту. Для диагностики лямблиоза используются анализы кала и серологические тесты.
Лечение включает применение противопротозойных препаратов, таких как метронидазол или нидазол, которые назначаются в зависимости от возраста и состояния ребенка. Врачи также рекомендуют соблюдать диету, исключая жирные и тяжелые продукты, чтобы облегчить состояние. Параллельно важно поддерживать иммунитет ребенка с помощью витаминов и правильного питания. Регулярные медицинские осмотры и профилактика помогут избежать повторного заражения и поддержат здоровье ребенка.

Острая форма болезни
Если в организм крохе в одно время проникло большое число паразитов, то болезнь в этой ситуации переходит в острую форму и довольно быстро развивается. У детей неожиданно пропадает аппетит, он практически полностью отказывается от приема пищи. Малыша может тошнить, а иногда случается и рвота. Также присутствуют такие симптомы лямблиоза у детей как высокая температура, вздутие живота, большое количество высыпаний (они напоминают краснуху). Как правило, такая форма болезни бывает у деток до 3 лет. Это из-за того, что у них еще слабый иммунитет.
Обычно на этом этапе доктору трудно установить точный диагноз. И тогда малыша лечат не от лямблиоза, а от острого вида инфекции кишечника. В итоге болезнь переходит в хроническую форму. У крохи время от времени болит живот, происходит расстройство кишечника, малыш худеет.
Происходит изменение в кожном покрове, он меняет цвет и приобретает бледный оттенок. Язык у такого малыша желтоватый.
Как обнаружить их у маленьких деток
Симптомы этого заболевания у деток не имеет отличий от признаков, которые появляются у взрослых людей. Поэтому родителям следует наблюдать не просто за поведением крохи и следить за его внешними показателями, но и присмотреться к себе.
Лямблиоз у детей вызывает много беспокойства у родителей, и мнения о симптомах и лечении этого заболевания варьируются. Многие отмечают, что первыми признаками могут быть боли в животе, диарея и общая слабость. Некоторые родители сообщают о том, что их дети становятся капризными и теряют аппетит. Важно помнить, что симптомы могут быть схожи с другими заболеваниями, поэтому диагностика должна проводиться врачом.
Что касается лечения, то большинство специалистов рекомендуют антипаразитарные препараты, такие как метронидазол или нидазол. Однако многие родители также подчеркивают важность поддерживающей терапии, включая пробиотики и сбалансированное питание для восстановления микрофлоры кишечника. Кроме того, некоторые родители делятся опытом использования народных средств, таких как отвар из полыни или чеснока, но всегда подчеркивают, что такие методы следует применять с осторожностью и после консультации с врачом. В целом, комплексный подход к лечению и внимательное отношение к состоянию ребенка являются ключевыми факторами в борьбе с лямблиозом.

Признаки заболевания у малышей
К основным признакам лямблиоза у детей относят:
- Температура не повышается за 37.5 градусов. Такая температура часто повышается накануне сна на протяжении 14 дней каждый день.
- Трудности с пищеварением – родителей крохи беспокоят расстройства желудка, которое проявляет себя в виде то запоров, то поносов. И родители чаще всего не могут понять, что стало этому причиной. А конкретно определить какие продукты спровоцировали расстройства. Такие сбои в работе пищеварительной системы на протяжении нескольких дней могут вызвать дисбактериоз, и лечить его придется очень долго.
Распространенным является признак скрипа зубов во сне (он не является показательным симптомом). Этот признак в основном критикуется учеными-исследователями, однако во многих случаях этот признак наблюдается у больного малыша. Объясняют его влиянием на ЦНС, в некоторой степени.
- Дети очень быстро устают, у них появляются жалобы на слабость в руках и ногах, им трудно сконцентрироваться на одном занятии. У школьников во время болезни снижается уровень успеваемость, потому что есть нарушения в памяти.
- Детки могут чувствовать боль в животике. Маленькие дети не могут показать, где именно у них болит, и определить эпицентр боли можно только прощупывая живот. Малыши чуть старше прямо показывает на боль в правом подреберье, а это может говорить о том, что паразиты локализуются в печени.
- У малыша наблюдаются сильные кашлевые приступы (вплоть до удушливых приступов), которые появляются без очевидных на это причин.
- Также могут увеличиваться лимфатические узлы, к чему тоже нет позывов – кроха не простудился, горлышко не красное.
- Лямблии у ребенка могут вызвать сыпь (которая носит аллергический характер). Это обосновывается тем, что в крови повышается содержание эозинофилов – специальные элементы, вырабатываемые кровью в целях борьбы с цистами.
Понаблюдайте за своим ребенком. Если он еще очень маленький, то он станет капризничать и тянуть ножки к животику, а это говорит о месте боли. Как правило, это случается после недолгого отдыха на животике.
Диагностика заболевания у малышей
Чем опасен лямблиоз? Опасность состоит в том, что если вовремя не обнаружить лямблиоз у детей, то это может привести к большому количеству различных неприятностей со здоровьем. Помимо этого, от формы степени запущенности болезни вылечить лямблии у ребенка становится весьма трудно.
Именно поэтому поставить правильный диагноз на начальном этапе будет лучше всего. Для обнаружения лямблии у детей используют некоторые методы. Иногда хватит и одного исследования, а порой доктор вынужден использовать полный комплекс, и после этого доктор скажет, чем лечить это заболевание.
Как проверяют на лямблиоз деток
- Серологическое исследование. В последнее время весьма распространен данный вид исследования. В этом исследовании проверяют кровь зараженного человека на определения особых антител, которые начинает вырабатывать организм малыша при попадании лямблий в организм. Но у этого способа есть недостаток: он эффективен только в течение первых 3-4 недель после проникновения паразитов в организм.
- Исследуют стул. Для этого исследования малыш сдает кал на анализ. Врач-лаборант изучает каловую массу на предмет наличия цист. Но это исследование так же не всегда позволяет выявить паразиты.
- Дуоденальный способ. Для его проведения малышу должно быть больше 10 лет. В этой ситуации чудесный результат дает исследование желчи. В ней паразиты лямблии сосредоточены практически всегда, если малыш заразился ими. У очень маленьких деток этот способ почти не используются, потому что для маленьких деток такая процедура очень сложная.
Лечение
Родители сразу же задумываются о том, как вылечить лямблиоз, чем вылечить, какие препараты подойдут, и какое лекарство точно поможет. Задача лечения заключается в устранении лямблий из тонкого кишечника. Как правило, малышам легче переносить это заболевание. Но лечение лямблий у детей может затягиваться надолго. Есть риск и повторного заражения. Лечение лямблиоза у детей схема проводится в три этапа:
- Как лечить лямблии у детей. Начать следует с диеты, употреблять определенные препараты – ферменты и сорбенты. Все это поможет работе системы пищеварения, уменьшить степень интоксикации, подкорректировать иммунологический статус.
На этой стадии также прописывают антигистаминные препараты. Этот этап длится 7-14 дней.
- Лечить лямблиоз у детей, используя противопаразитные препараты. После старта лечения могут увеличиться признаки лямблии у детей (в течении первых трех дней): боль в животике, диарея, сыпь на кожном покрове. Это нормальная реакция, и лечение не прекращается. Если форма острая, то лечение изменяется: первым делом используют лекарства против самих паразитов. Терапия длится примерно неделю.
- Восстановительный этап. Все методы лечения направляются на то, чтобы восстановить силы организма. Не прекращается терапия с ферментами, к ней добавляют пробиотик для стабилизации кишечной флоры, иммуностимуляторы. Прописывают диету, в которой высокое содержание пектина. Последняя стадия длится 2-3 недели.
Все медикаменты прописывает только доктор. Учитывает такие важные аспекты: результативность, безопасность (препарат должен подходить малышу по возрасту), отсутствие аллергии на компоненты медикамента, наличие заболевания. Если возникли любые побочные эффекты, то следует сразу обратиться к доктору. Если у крохи выражена чувствительность к лекарству, то доктор его меняет на подходящее.
Профилактика болезни
Профилактические меры по лямблиозу проходят по таким правилам:
- Следите за едой и продуктами, которыми питается больной и вся семья. Не забывайте мыть овощи и фрукты со специально предназначенными средствами, которую удаляют лишнюю грязь, в том числе и опасные бактерии.
- Пить давайте крохе кипяченную или отфильтрованную водичку.
- Следите и приучайте малыша следить за собственной гигиеной. Научите его мыть ручки перед обедом и после любой прогулки на улице, посещения публичных мест.
- Отучайте кроху от плохих привычек. Малыш не должен тянуть пальцы в рот, грызть ногти или предметы.
- Не позволяйте малышу купаться в открытых источниках воды без уверенности в качестве воды (и сами избегайте таких водоемов).
Для избежания заражения у малыша, необходимо в обязательном порядке проходить обследование. Не позволяйте ребенку тесно общаться с животным, а если он поиграл с животным, особенно уличным, сразу идите мыть руки. Если животное живет у вас дома, то мойте пол как можно чаще, используя специальные моющие средства.
Если Вы заметили лямблии у детей признаки, которых описаны выше, то не впадайте в панику. Сразу отправляйтесь к доктору и выскажите свои опасения. Доверьтесь врачу и выполняйте все его рекомендации, тогда все будет хорошо. Проведут обследование малыша и назначат подходящее лечение, которое будет проходить под руководством вашего врача.
Не занимайтесь лечением самостоятельно, это только навредит здоровью вашего малыша. Заболевание может перейти в хроническую форму, поэтому с этим шутить не надо. Лучше довериться профессионалам и начать своевременное лечение.
Вопрос-ответ
Как правильно лечить лямблиоз у детей?
Наиболее эффективным препаратом в настоящее время является нифурател (Макмирор). Эффективность терапии нифурателом (Макмирор) в течение 7 дней из расчета по 15 мг/кг массы тела 2 раза/сут. , по данным различных авторов, превышает 96%, метронидазолом – составляет 12–70%, альбендазолом – 33–90%.
Какие симптомы лямблиоза у детей?
Болезненность в области живота, частое вздутие, снижение аппетита, изменение предпочтений в еде, нарушения стула: понос и/или запор, кал становится светло-коричневым или желтым, кашицеобразным, неоднородным, Ещё
Какой препарат убивает лямблии у детей?
Секнидокс убивает лямблий, нарушая синтез их ДНК и жизнедеятельность клетки. Он хорошо всасывается и имеет высокую биодоступность – 80%, то есть способен быстро создавать высокие концентрации в органах, в которых паразитируют лямблии.
Как правильно лечить лямблии?
На первом этапе назначаются диетотерапия и разгрузочные дни, а также прием желчегонных, а при необходимости и антигистаминных препаратов. На втором этапе пациент принимает специальные антипротозойные препараты, выписанные врачом. Для избавления от лямблий часто назначается не один, а два курса.
Советы
СОВЕТ №1
Регулярно проверяйте детей на наличие лямблий, особенно если они посещают детские сады или общие игровые площадки. Раннее выявление инфекции поможет избежать осложнений и распространения заболевания.
СОВЕТ №2
Обратите внимание на симптомы, такие как частые боли в животе, диарея, усталость и потеря аппетита. Если вы заметили эти признаки, немедленно обратитесь к врачу для диагностики и назначения лечения.
СОВЕТ №3
Следите за гигиеной детей: учите их мыть руки перед едой и после посещения туалета. Это поможет снизить риск заражения лямблиями и другими кишечными инфекциями.
СОВЕТ №4
При лечении лямблиоза следуйте рекомендациям врача и не прерывайте курс лечения, даже если симптомы исчезли. Это поможет предотвратить рецидив и обеспечит полное выздоровление.